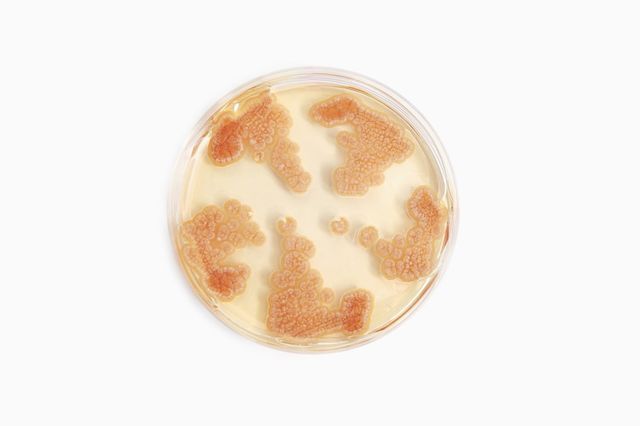

Тетрациклин Новое Поколение

💣 👉🏻👉🏻👉🏻 ИНФОРМАЦИЯ ДОСТУПНА ЗДЕСЬ! КЛИКАЙ 👈🏻👈🏻👈🏻
Тетрациклин: аналози на новото поколение
Антибиотики: пенициллин и тетрациклин
Тетрациклин - инструкция по применению, формы выпуска и аналоги
Антибиотики широкого спектра действия в таблетках
Антибактериальные препараты : Farmf | литература для фармацевтов
Список антибиотиков широкого спектра действия нового поколения
Новое поколение антибиотиков в . . . - uctm .ru
Тетрациклин курам как давать
Список эффективных антибиотиков нового поколения
Самый сильный антибиотик широкого спектра - Антибиотики
Действие Таблеток Линдинет 20
Восстановление Микрофлоры После Тержинана
Метиленовый Синий Как Поить Куриц
Но дори и днес в трудни ситуации, лекарите често препоръчват тетрациклин: аналозите на новото поколение успешно се справят с болестта . Какво представляват тетрациклините (начин на действие)
В конце прошлого столетия было разработано новое поколение тетрациклинов — глицилциклины (тигециклин) . От классических тетрациклинов тигециклин отличает его способность продлевать механизмы резистентности микроорганизмов к тетрациклинам .
lekhar .ru › lekarstva › protivomikrobnye-preparaty › tetraciklin-instrukciya-po-primeneniyu
Тетрациклиновая глазная мазь Выпускается в тубах по 3 или 10 грамм . Концентрация глазной мази отличается от обычной и составляет 1% . Внешние свойства аналогичны простой тетрациклиновой мази . Способ применения Применяют препарат местно . Наносят каждые 2-4 часа за нижнее веко (на каждом глазу) . Продолжительность лечения зависит от формы болезни .
Первое поколение используются в лечении чумы и туберкулеза только в сочетании с тетрациклином . Третье и четвертое при туберкулезе, сепсисе, тяжелых госпитальных инфекциях вроде пневмоний .
Бициллин-5 Новое поколение макролидных АБ имеет преимущество: + Высокая биодоступность + Широкий спектр антибактериального действия + Длительный период полувыведения Почечный путь экскреции + Бактерицидное действие в небольших дозах Препараты выбора при наличии атипичных возбудителей (микоплазма, хламидия) + Макролиды Пенициллины Аминогликозиды
Как работают антибиотики нового поколения? В отличие от лекарственных средств из группы антисептиков, антибиотик обладает должным терапевтическим эффектом не только после наружного нанесения, но и действует системно после перорального, внутривенного, внутримышечного использования . Антибиотики нового поколения способны:
Данный антибиотик широкого спектра действия, группа - тетрациклины нового поколения . В качестве активного вещества выступает доксициклин . Врачи этот вид антибиотика назначают для лечения простатита, кишечных инфекций и разного рода простудных заболеваний . Дисбактериоза практически не вызывает; РУЛИД ( Rulid ) .
vseantibiotiki .ru › antibiotiki-shirokogo-spektra › tetraciklin-kuram-kak-davat .html
Тетрациклиновая глазная мазь Выпускается в тубах по 3 или 10 грамм . Концентрация глазной мази отличается от обычной и составляет 1% . Внешние свойства аналогичны простой тетрациклиновой мази . Способ применения Применяют препарат местно . Наносят каждые 2-4 часа за нижнее веко (на каждом глазу) . Продолжительность лечения зависит от формы болезни .
morehealthy .ru › material › spisok-effektivnykh-antibiotikov-novogo-pokoleniya-3405 .html
3 поколение - пенициллины с широким спектром действия (ампициллин, амоксициллин) . Начиная с 3-го поколения, антибиотико негативно воздействуют и на грамположительные бактерии, и на грамотрицательные .
Тетрациклины противопоказаны детям до 8 лет, беременным и кормящим женщинам, людям с печеночно-почечной недостаточностью (исключение - доксициклин) . Возможные побочные эффекты: головокружения, головные боли, расстройства желудочно-кишечного тракта, индивидуальная непереносимость .
Симбикорт Цена В Аптеках Краснодара
Левофлоксацин Таблетки Для Чего Применяется
Прогинова Или Цикло Прогинова Что Лучше
Мелоксикам Таблетки Для Кошек
Средство От Перхоти В Аптеках Низорал
Клайра Цена В Кургане
Ноопепт Цена В Аптеках Кемерово
Комбилипен И Никотиновая Кислота Совместимость Одновременного
Гроприносин 1000 Цена
Иван Чай Влияние
Энтерофурил Доставка
Мукосат Уколы Что Лечит
Коллаген Ультра Для Суставов Отзывы
Метиленовый Синий 1 Цена
Тиамина Хлорид Применению В Ампулах
Номидес 30 Мг Инструкция По Применению Цена
Аналоги Глиатилина В Капсулах Отзывы Врачей
Сколько Стоит Мексидол В Ампулах
Нимулид Пакетики
Коэнзим Q10 1
Отличие Конвулекс От Депакина
Глицин Разжижает
Клиндамицин В М
Сколько Стоит Тексаред Уколы
Аналоги Линекс Форте Для Больных Сахарным Диабетом
Ибупрофен Таблетки Цена Вита Аптека
Свечи Папаверин При Беременности На Ранних
Кориандр В Духах
Данцил Сколько Стоит
Отличие Нутроф Тотал От Нутроф Форте
Протамин Бинергия
Розулип 20
Везикар Цена В Нижнем Новгороде
Энтерофурил Сироп Аналоги Цена
Ацетат Кальция
Как Готовить Фурацилин Для Полоскания
Масло Магнезиум
Папаверин Гидрохлорид Свечи Цена
Галазолин Капли Для Глаз
Как Открыть Капли Глазные Капли Комбинил
Беременность Ранний Срок На Дюфастон Выделения
Гриппферон Цена В Ельце
Фосфоглив Форте Планета Здоровья
Протаргол Изофра Полидекса
Сальбутамол В Комбинации
Препарат Мексидол Применение Аналоги
Преднизолон Таблетки Гедеон Рихтер
Кордиамин Показания К Применению Капли
Пимафуцин Или Нистатин Что Лучше При Молочнице
Отчего Гевискон
Темная Луна Ренни Заклинание Эллен Ринг
Урисан Капсулы
Клайра Отзывы Женщин После 40 При Климаксе
Урисан Показания К Применению
Кордарон 200 Мг Отзывы Пациентов
Пироксикам Цена В Алматы
Витрум Центрум Плюс
Ренгалин Жидкий Инструкция По Применению Детям
Эдарби Прием Отзывы
Выделения При Отмене Утрожестана
Шампунь 200 Мл Пантовигар
Кудесан Производитель Германия
Нимесил Порошок Растворить В Горячей Воде
Рамиприл Акрихин Отзывы
К Чему Просыпать Перец
После Лактофильтрума Пошли Прыщи На Лице
Метромикон Нео Отзывы
Милдронат В М
Доктор Мом От Кашля Цена Отзывы
Жидкость От Запаха Ног Формидрон Цена
Кандидерм Крем Для Чего Применяется
Офтолик Цена Спб
Лактофильтрум При Тошноте
Пивные Дрожжи Можно Потолстеть
Детралекс Архангельск
Триттико 150 Цена
Технология Изготовления Магния Сульфата
Гепон Мазь При Трофических Язвах Отзывы
Порошок Для Печени Гепа Мерц Цена
Верошпирон Цена В Туле
Цианокобаламин Вит В12
Какие Таблетки Кашля Курильщика
Препарат Кудесан Цена
Виксипин Глазные
Рифампицин Инструкция По Применению Цена
Эниксум 0.4 Цена Инструкция
Nutrilite Кальций Магний Витамин D Комплекс
Люголь Относится К Группе
Стрепсилс От Горла Цена
Кто Производит Симбикорт Турбухалер
Нурофен Детский Снимают С Производства 2022
Город Мирный Крым Фото
Бонджигар Цена В Москве В Аптеках
Аптека Ру Гепарин
Синтез Тирозина Из Фенилаланина
Снуп Дог Покурил В Белом Доме
Сердечные Препараты Панангин
Кальций Oh
Рабепразол Инструкция Аналоги Цена Отзывы
Нексиум 20 Мг Аналоги
Тетрациклин Новое Поколение
















































_and_a_dead_Human_neutrophil_-_NIAID.jpg)